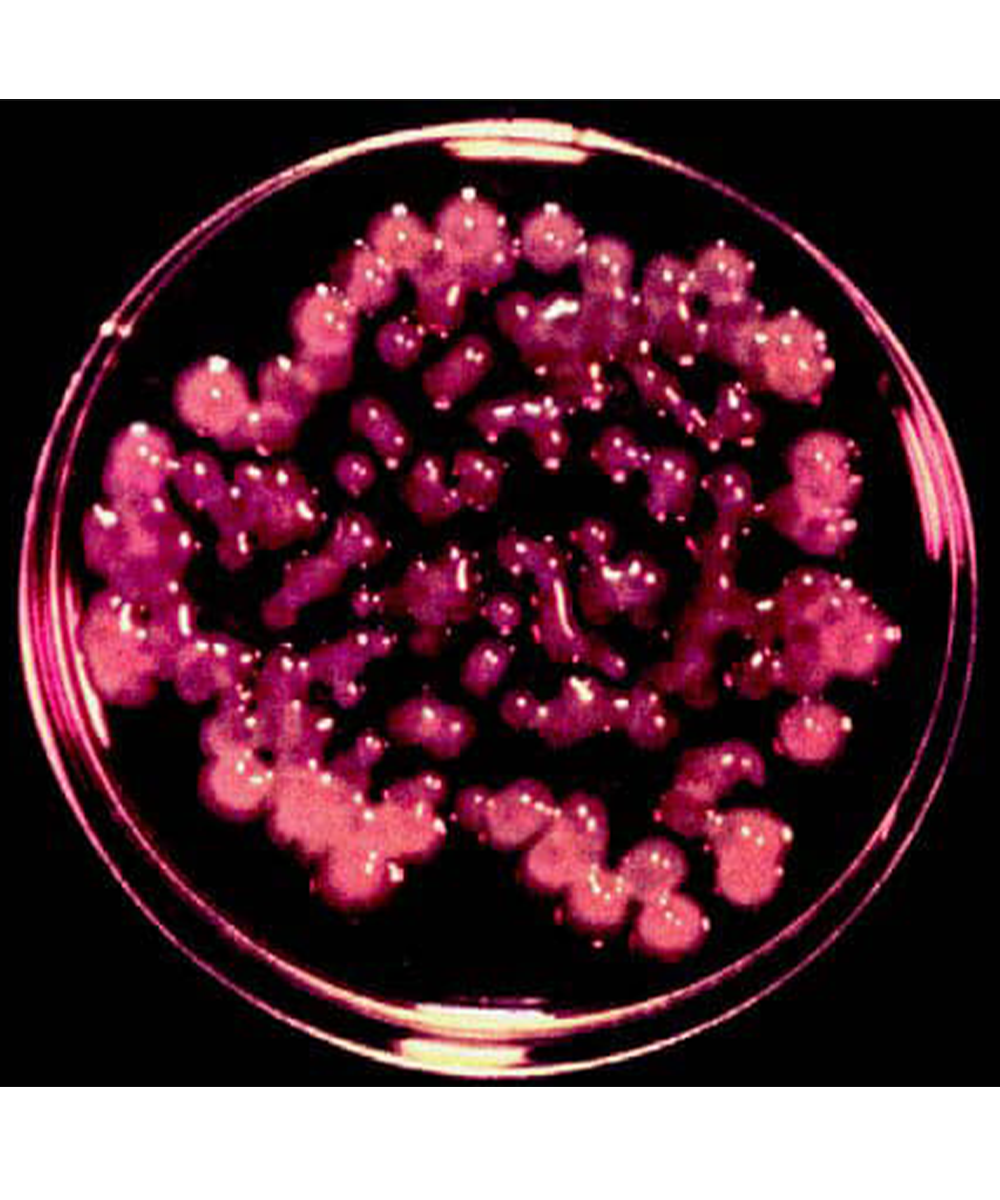

Tetrapod zinc oxide (t-ZnO) is a functional particle with excellent properties. These properties are derived from its unique particle morphology and a large number of oxygen vacancies on the particle surface, which produce excellent physical and chemical properties.
How Does It Function?
Based on the excellent performance and outstanding characteristics of t-ZnO, when applied to skin with acne/pimples, it can add a high immune response effect on the basis of the traditional astringent effect of zinc oxide, killing various viruses and bacteria.

Acne | Pimples
Particularly effective in acute outbreaks and severe symptoms

Blackheads | Whiteheads
Non-inflammatory acne damage

Acne Marks | Acne Scars | Acne Pits
Secondary lesions such as red/black/brown acne marks, acne scars, and scars on the skin surface

Pustules丨Nodules丨Cysts
Inflammatory papules

Herpes Labialis Virus

Minor Burns | Sunburn
Wound healing

Before

After
Key Ingredients

Sodium Hyaluronate(<100 kDa) is highly favored in the skin care and beauty fields due to its excellent skin penetration ability, promotion of skin repair, increase of skin elasticity, anti-aging effects and strengthening of skin barrier.
It can promote the production of collagen and elastin in the skin, accelerate the skin's natural healing process, and enhance the skin's ability to retain water
It is a natural resin with significant antibacterial and anti-inflammatory properties. In cosmetics, it is used to provide skin soothing, firming and cleansing effects.
100%
Pure natural ingredients
T-ZnO serum uses a lot of natural extracts to ensure safety for sensitive skin